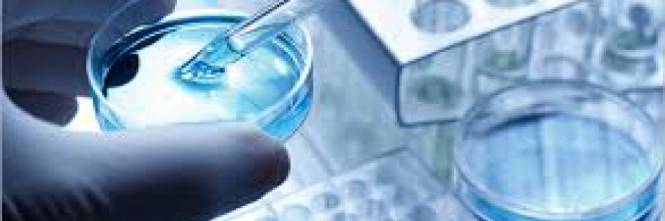

Lettera aperta a Matteo Bassetti, “Pinocchi in camice”
Chiarissimo Professore, l’ho conosciuta e apprezzata come riferimento televisivo durante la pandemia, in quanto, avendo vissuto per 48 anni come Professore di Chimica Generale

Chiarissimo Professore, l’ho conosciuta e apprezzata come riferimento televisivo durante la pandemia, in quanto, avendo vissuto per 48 anni come Professore di Chimica Generale

di Gino Santini – Da “Omeopatia33” del 9 settembre 2022 Lo ammetto: anche io, come molti della mia generazione, sono cresciuto a pane e SuperQuark.

“Pronti a condannare comportamenti negligenti” Milano, 24 settembre 2019 – “Quello che si apre questa mattina ad Ancona non è, e non deve diventare, un

Da “CityRumors.It” del 2 settembre 2016 Pescara. Anche il Comune di Pescara aderisce, con la collaborazione della pediatra e consigliera comunale Tiziana Di Giampietro, a

Da “La Stampa” del 27 agosto 2016 di Fabio Todaro L’iniziativa nella provincia di Ascoli Piceno. Ma alcuni scienziati: «È una falsa cura». La replica

Da “Il Sole 24 Ore – Sanità” del 5 agosto 2016 di Rosanna Magnano Dal 2019 in poi potrebbe restare sul mercato solo un prodotto

Da “Agenzia ANSA” del 6 agosto 2016 Le cure si integrano per una migliore qualita’ delle cure e della vita di Anna Lisa Antonucci Il

Il master offre ai partecipanti strumenti di conoscenza teorici e operativi utili alla formazione di figure professionali in grado di integrare gli aspetti gestionali ed

Da “Il Giunco” del 9 luglio 2016 FIRENZE – Il Centro di medicina integrata dell’ospedale di Pitigliano è stato cooptato quale centro collaborante del master

Da “Sanità Informazione” del 28 giugno 2016 di Cesare Buquicchio Aumenta l’uso della medicina omeopatica da parte dei cittadini statunitensi. Lo rivela una recente indagine

Da “Quotidiano Sanità” del 7 giugno 2016 Lo ha ricordato l’assessore regionale alla Salute che oggi pomeriggio ha visitato il Centro Fior di Prugna, nel

Da “Quotidiano Sanità” del 6 giugno 2016 La professione medica è basata sulla relazione medico-paziente, e se pur tale relazione è stata ed è soggetta

Da “Il Giornale” del 31 maggio 2016 Più fondi per la ricerca scientifica. Con questo impegno si aprono i lavori dell’assemblea annuale di Omeoimprese, l’associazione

Da “DoctorNews” del 20 maggio 2016 Se non verranno prese misure adeguate, entro il 2050 la resistenza agli antibiotici potrebbe rappresentare una causa di morte

Da “Ask-A-News” del 18 maggio 2016 Alternativa, non convenzionale, complementare. I nomi per definire l’universo della medicina “non ufficiale” sono tanti ed evidenziano una natura

Da “La Stampa” del 22 aprile 2016 di Noemi Penna La dottoressa Durando e omeopata è accusata di omicidio colposo per la morte di Marina,

Da “La Stampa” del 21 aprile 2016 Mentre il dott. Salvo di Grazia, “medico per professione e passione da sempre”, su “Il fatto quotidiano.it”. risolve

Da “Quotidiano Sanità” del 14 aprile 2016 Non ha dubbi la manager della filiale italiana della più importante azienda omeopatica a livello mondiale: “L’omeopatia, o meglio

Da “Newsletter OMCeO Roma” dell’11 aprile 2016 “Attacchi superficiali e sansazionalistici, poco spazio a opinioni e repliche, ma soprattutto tantissima confusione sul tema, spesso anche

Da “Quotidiano Sanità” dell’11 aprile 2016 L’indagine indipendente sulla ricerca d’informazioni di salute in Internet, è stata condotta su due campioni: 745 internauti e 872 tra

Da “Quotidiano Sanità” dell’11 aprile 2016 La ricerca, diffusa oggi dall’Amiot, ed effettuata con oltre 2mila intervista su un campione rappresentativo della popolazione maggiorenne italiana,

Da “Today” dell’8 aprile 2016 In Italia aumenta l’utilizzo dei medicinali complementari: è quanto emerge da un sondaggio indetto in occasione della Giornata internazionale dell’omeopatica

Da “Doctor33” di venerdì 8 aprile 2016 Mercato ampio e segnali positivi per il futuro dell’omeopatia. Il primo è certificato dall’Istat, i cui dati indicano

Da “Quotidiano Sanità” dell’8 aprile 2016 Gentile Direttore, vogliamo ringraziare Ivan Cavicchi per il rilievo dato alla nostra esperienza, dedicandole una bella riflessione su queste

Da “Repubblica – Medicina” dell’11 gennaio 2016 Medicina dolce. C’è troppa discrezionalità da parte del medico. Che invece deve essere coscienzioso e riconoscere i limiti

Da “Il tempo” dell’8 aprile 2016 di Sabrina Biraghi Il 20% degli italiani la usa almeno una volta l’anno, anche per i piccoli Gorga (Omeoimprese):

Da “Quotidiano Sanità” dell’11 marzo 2016 Così l’assessore in visita presso la prima struttura ospedaliera pubblica a livello nazionale nella quale alla medicina tradizionale si affianca

Da “Quotidiano Sanità” del 6 aprile 2016 Choosing wisely o scegliere saggiamente sembrerebbe proporsi come una rivoluzione paradigmatica della medicina di straordinaria portata riformatrice nella quale accanto

Da “Repubblica Blog” del 5 aprile 2016 Quando accadono casi come quelli di Torino, dove alcune persone sono morte perché avrebbero seguito le teorie di

Da “Repubblica” del 4 aprile 2016 di Giuseppe Del Bello Non ci sono studi che ne dimostrino l’efficacia. Eppure molti medici la utilizzano. E in

Chiarissimo Professore, l’ho conosciuta e apprezzata come riferimento televisivo durante la pandemia, in quanto, avendo vissuto per 48 anni come Professore di Chimica Generale

di Gino Santini – Da “Omeopatia33” del 9 settembre 2022 Lo ammetto: anche io, come molti della mia generazione, sono cresciuto a pane e SuperQuark.

“Pronti a condannare comportamenti negligenti” Milano, 24 settembre 2019 – “Quello che si apre questa mattina ad Ancona non è, e non deve diventare, un

Da “CityRumors.It” del 2 settembre 2016 Pescara. Anche il Comune di Pescara aderisce, con la collaborazione della pediatra e consigliera comunale Tiziana Di Giampietro, a

Da “La Stampa” del 27 agosto 2016 di Fabio Todaro L’iniziativa nella provincia di Ascoli Piceno. Ma alcuni scienziati: «È una falsa cura». La replica

Da “Il Sole 24 Ore – Sanità” del 5 agosto 2016 di Rosanna Magnano Dal 2019 in poi potrebbe restare sul mercato solo un prodotto

Da “Agenzia ANSA” del 6 agosto 2016 Le cure si integrano per una migliore qualita’ delle cure e della vita di Anna Lisa Antonucci Il

Il master offre ai partecipanti strumenti di conoscenza teorici e operativi utili alla formazione di figure professionali in grado di integrare gli aspetti gestionali ed

Da “Il Giunco” del 9 luglio 2016 FIRENZE – Il Centro di medicina integrata dell’ospedale di Pitigliano è stato cooptato quale centro collaborante del master

Da “Sanità Informazione” del 28 giugno 2016 di Cesare Buquicchio Aumenta l’uso della medicina omeopatica da parte dei cittadini statunitensi. Lo rivela una recente indagine

Da “Quotidiano Sanità” del 7 giugno 2016 Lo ha ricordato l’assessore regionale alla Salute che oggi pomeriggio ha visitato il Centro Fior di Prugna, nel

Da “Quotidiano Sanità” del 6 giugno 2016 La professione medica è basata sulla relazione medico-paziente, e se pur tale relazione è stata ed è soggetta
Da “Il Giornale” del 31 maggio 2016 Più fondi per la ricerca scientifica. Con questo impegno si aprono i lavori dell’assemblea annuale di Omeoimprese, l’associazione

Da “DoctorNews” del 20 maggio 2016 Se non verranno prese misure adeguate, entro il 2050 la resistenza agli antibiotici potrebbe rappresentare una causa di morte

Da “Ask-A-News” del 18 maggio 2016 Alternativa, non convenzionale, complementare. I nomi per definire l’universo della medicina “non ufficiale” sono tanti ed evidenziano una natura

Da “La Stampa” del 22 aprile 2016 di Noemi Penna La dottoressa Durando e omeopata è accusata di omicidio colposo per la morte di Marina,

Da “La Stampa” del 21 aprile 2016 Mentre il dott. Salvo di Grazia, “medico per professione e passione da sempre”, su “Il fatto quotidiano.it”. risolve

Da “Quotidiano Sanità” del 14 aprile 2016 Non ha dubbi la manager della filiale italiana della più importante azienda omeopatica a livello mondiale: “L’omeopatia, o meglio

Da “Newsletter OMCeO Roma” dell’11 aprile 2016 “Attacchi superficiali e sansazionalistici, poco spazio a opinioni e repliche, ma soprattutto tantissima confusione sul tema, spesso anche

Da “Quotidiano Sanità” dell’11 aprile 2016 L’indagine indipendente sulla ricerca d’informazioni di salute in Internet, è stata condotta su due campioni: 745 internauti e 872 tra

Da “Quotidiano Sanità” dell’11 aprile 2016 La ricerca, diffusa oggi dall’Amiot, ed effettuata con oltre 2mila intervista su un campione rappresentativo della popolazione maggiorenne italiana,

Da “Today” dell’8 aprile 2016 In Italia aumenta l’utilizzo dei medicinali complementari: è quanto emerge da un sondaggio indetto in occasione della Giornata internazionale dell’omeopatica

Da “Doctor33” di venerdì 8 aprile 2016 Mercato ampio e segnali positivi per il futuro dell’omeopatia. Il primo è certificato dall’Istat, i cui dati indicano

Da “Quotidiano Sanità” dell’8 aprile 2016 Gentile Direttore, vogliamo ringraziare Ivan Cavicchi per il rilievo dato alla nostra esperienza, dedicandole una bella riflessione su queste

Da “Repubblica – Medicina” dell’11 gennaio 2016 Medicina dolce. C’è troppa discrezionalità da parte del medico. Che invece deve essere coscienzioso e riconoscere i limiti

Da “Il tempo” dell’8 aprile 2016 di Sabrina Biraghi Il 20% degli italiani la usa almeno una volta l’anno, anche per i piccoli Gorga (Omeoimprese):

Da “Quotidiano Sanità” dell’11 marzo 2016 Così l’assessore in visita presso la prima struttura ospedaliera pubblica a livello nazionale nella quale alla medicina tradizionale si affianca

Da “Quotidiano Sanità” del 6 aprile 2016 Choosing wisely o scegliere saggiamente sembrerebbe proporsi come una rivoluzione paradigmatica della medicina di straordinaria portata riformatrice nella quale accanto

Da “Repubblica Blog” del 5 aprile 2016 Quando accadono casi come quelli di Torino, dove alcune persone sono morte perché avrebbero seguito le teorie di

Da “Repubblica” del 4 aprile 2016 di Giuseppe Del Bello Non ci sono studi che ne dimostrino l’efficacia. Eppure molti medici la utilizzano. E in
Questo sito utilizza cookie tecnici e di profilazione.
Puoi accettare, rifiutare o personalizzare i cookie premendo i pulsanti desiderati.
Chiudendo questa informativa continuerai senza accettare.
Impostazioni privacy
Questo sito utilizza i cookie per migliorare la tua esperienza di navigazione su questo sito.
Visualizza la Cookie Policy Visualizza l'Informativa Privacy
Vimeo è un servizio di visualizzazione di contenuti video gestito da Vimeo, LLC. Questo servizio serve per integrare tali contenuti nelle proprie pagine.
Luogo del trattamento: Stati Uniti - Privacy Policy
YouTube è un servizio di visualizzazione di contenuti video gestito da Google Ireland Limited e permette a questo Sito Web di integrare tali contenuti all’interno delle proprie pagine.
Questo widget è impostato in modo che YouTube non salvi informazioni e cookie inerenti agli Utenti su questo Sito Web, a meno che non riproducano il video.
Luogo del trattamento: Irlanda - Privacy Policy
Google Maps è un servizio di visualizzazione di mappe gestito da Google Ireland Limited. Questo servizio serve ad integrare tali contenuti all’interno delle proprie pagine.
Luogo del trattamento: Irlanda - Privacy Policy
Gravatar è un servizio di visualizzazione di immagini gestito da Automattic Inc. che permette a Automattic Inc. di integrare tali contenuti all’interno delle proprie pagine.
Luogo del trattamento: Stati Uniti - Privacy Policy